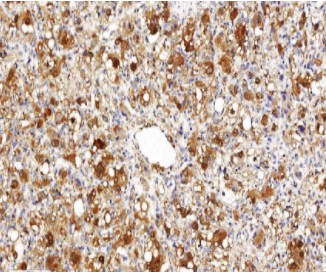

Protein Gene Product 9.5抗体试剂
Protein Gene Product 9.5抗体试剂
蛋白基因产物9.5
产品描述
Protein Gene Product 9.5(PGP 9.5)抗体是一种高度敏感且广泛应用的神经内分泌标志物,特异性识别神经元特异性泛素羧基末端水解酶(UCH-L1)。该抗体能有效标记神经元胞体、轴突及各种神经内分泌细胞,在病理诊断中主要用于神经内分泌肿瘤(如类癌、副神经节瘤)、神经母细胞瘤和黑色素瘤的鉴别。其独特优势在于能清晰显示皮肤神经纤维网结构,对评估神经浸润和微小神经纤维瘤具有重要价值,同时在阿尔茨海默病等神经退行性病变研究中可作为神经元完整性评估的可靠指标。
参考文献
产品信息
备案名称:
蛋白基因产物9.5(Protein Gene Product9.5)抗体试剂
备案证号:
粤深械备 20221640
产品型号:
DMRD0250
适用:
阳性部位:
细胞质/膜
预 处 理:
产品规格
| 类型 | 即用型 | 浓缩型 | ||||
| 规格 | 1ml | 3ml | 6ml | 10ml | 0.1ml | 0.2ml |


